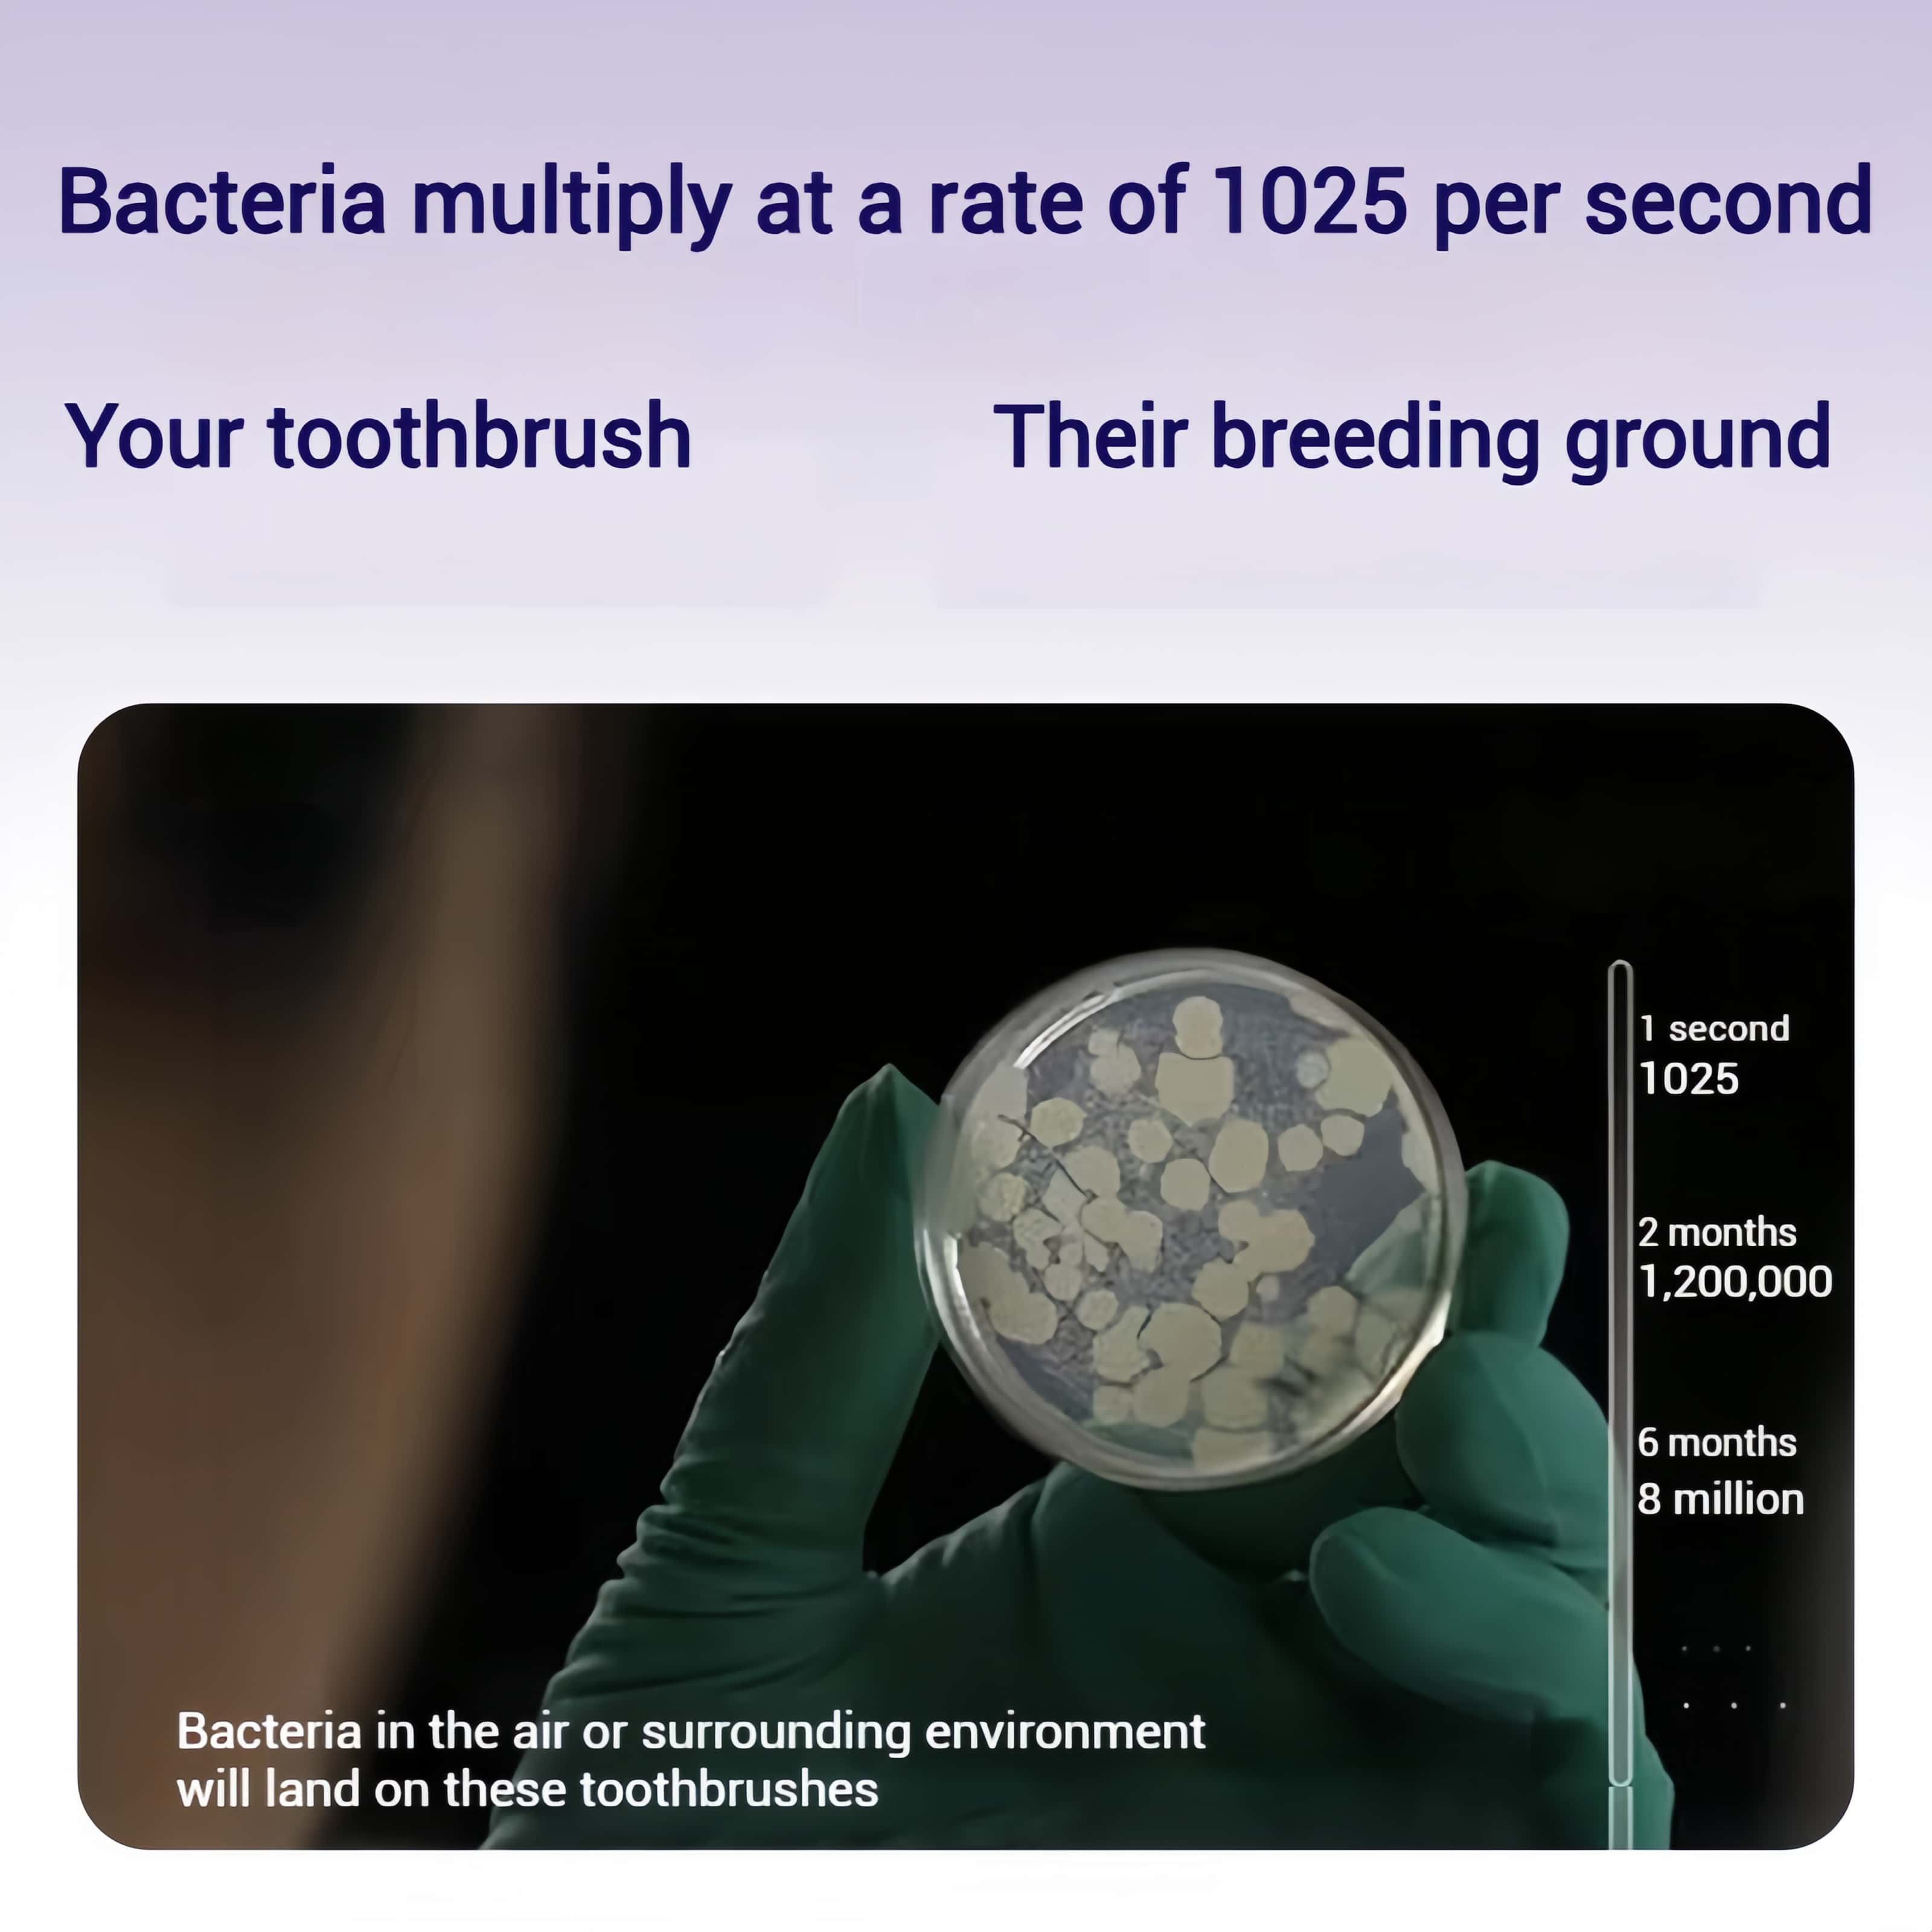

1
/
of
8
Orateeth Space Capsule UV Sonic Electric Toothbrush
Orateeth Space Capsule UV Sonic Electric Toothbrush
99.99% Bacteria Elimination, Travel-Friendly & Daily Oral Care Assurance.
No reviews
Regular price
$129.99
Regular price
Sale price
$129.99
Quantity
Couldn't load pickup availability
- More Than 50 Days Long Battery Life
- 45,000 Movements/min Maglev Motor
- High-speed Mode, 60s Clean Teeth
- Ultrasonic Active Noise Reduction Technology<36dB
- Imported DuPont High-elasticity Rounded Bristles
- UV Sterilization Space Capsule, 90s Smart Sterilization
- IPX7 Waterproof
Returns & Refunds
Returns & Refunds
Returns
orateeth offers a 15-day return policy. To issue the return, due to hygiene reasons, the product and its package shall remain its original form with tags on, plastic sealing film needs to be intact, receipt also needed. (The buyer is responsible for their own return shipping costs include all customs, duties, and taxes if the return is not due to a defective product or a merchant operation error.)
If any items (a) are returned after the specified return period; (b) have been physically damaged, modified, or damaged by liquids; or not covered by warranty are missing any parts, you will not receive any refund, replacement, or repair. Customers are also solely responsible to any duties, import taxes and brokerage fees imputable to repaired merchandise (the taxation, if any, will be on replacement parts and labor and transportation).
Please contact to support@orateeth.com for detailed return address before you issue return. Once your return request is accepted, further details will be sent to you. Logistics expenditure shall be covered by the buyer if the product is free from defect.
Damages and issues
orateeth provides a 2-year standard warranty, products registered on orateeth.com are eligible for an additional 1-year extended warranty*. Please inspect your order upon reception and contact us immediately if the item is defective, or damaged or if you receive the wrong item so that we can evaluate the issue and make it right.
Exchanges Conditions
This Warranty does not cover damage caused by:
·misuse or abusive use of the orateeth product, including physical abuse; damages by liquids;
·incorrect operation or not following the operation instructions (as stated in the User Manual or manufacturer’s instructions provided with the orateeth product);
·improper installation;
·incorrect or improper maintenance or failure to maintain the orateeth product;
·failure to clean or improper cleaning of the product;
·incorrect voltage or non-authorized electrical connections;
·adverse external conditions such as power surges and dips, thunderstorm activity, acts of terrorism, damage caused by vermin, or any other act or circumstance beyond orateeth control;
·exposure to excessive heat, moisture or dampness;
·exposure to abnormally corrosive conditions;
·use of non-authorized / non-standard, defective or incompatible parts; some wall quick chargers could be harmful to the orateeth devices. Please charge your orateeth product via authorized/standard charger to respect voltage security.
·password setting / resetting and computer virus;
·repair, modification or other work carried out on the orateeth product other than by orateeth Support Team;
Exchanges
We only replace items if they are defective or damaged. If you need to exchange it for the same item, send us an email at support@orateeth.com.
Refunds
We will notify you once we’ve received and inspected your return, and let you know if the refund was approved or not. If approved, you’ll be automatically refunded on your original payment method. Please remember it can take some time for your bank or credit card company to process and post the refund too.
These Rules are drafted in accordance with the laws of the Republic of Lithuania.
The relationships arising under these Rules shall be governed by the laws of the Republic of Lithuania.
All disputes arising from the implementation of these Rules shall be resolved through negotiations. In case of failure to reach an agreement, disputes shall be resolved in accordance with the procedure established by the laws of the Republic of Lithuania.
Shipping Policy
Shipping Policy
-
Order Delivery Timeline:
Processing Time: 5-7 business days.
Standard Delivery Time: 8-12 business days.
-
Shipment of Products:
The products dispatched from Orateeth's online store are currently shipped from Lithuania.
-
Shipping Fee:
We offer free shipping on orders over $30.
-
Shipping Destinations:
Currently, we ship to an extensive list of countries within US and European Union including Poland, Belgium, Czech Republic, Netherlands, Slovakia, Hungary, Germany, Austria, Denmark, Luxembourg, Slovenia, Finland, Sweden, Ireland, Great Britain, Spain, Italy, Portugal, France, Bulgaria, Greece, Croatia, Romania, Lithuanian, Iceland, Swirtzerland.
-
Customs/ Import Charges:
We've got it covered. The price displayed at your checkout is final as Orateeth online store handles all customs, duties and taxes. There will be no additional surcharges after placing your order.
These Rules are drafted in accordance with the laws of the Republic of Lithuania.
The relationships arising under these Rules shall be governed by the laws of the Republic of Lithuania.
All disputes arising from the implementation of these Rules shall be resolved through negotiations. In case of failure to reach an agreement, disputes shall be resolved in accordance with the procedure established by the laws of the Republic of Lithuania.
Warranty Policy
Warranty Policy
Standard Warranty
Orateeth offers a standard warranty valid for two (2) years from the date of purchase or the warranty period required by applicable laws, whichever is longer.If your Orateeth product is found to be defective during this period, Orateeth will repair or replace it free of charge in accordance with the terms outlined in this policy.
Warranty Coverage
Orateeth’s warranty covers defects in materials or workmanship under normal consumer use. It does not cover the following:
-
Cosmetic damage (e.g., scratches)
-
Damage caused by: · Normal wear and tear · Accidents, misuse, or exposure to dirt or water · Unauthorized tampering or repairs · Improper use or failure to follow care instructions · Charging errors or using non-Orateeth chargers · Commercial use or modifications to the product
Terms & Conditions
-
Repair or Replacement: If a defect is confirmed during the warranty period, Orateeth will repair or replace the product at no cost. Replacement products may differ in color or model but will be of equivalent value.
-
Proof of Purchase: To claim the warranty, you must provide both the original proof of purchase (e.g., sales receipt) and the extended warranty confirmation email. Customers are encouraged to print and securely store these documents.
-
Geographic and Purchase Provider Limitations: This extended warranty only applies to products which are distributed by UAB Mbrush (shown on the product packaging) and purchased in Europe and the UK.
Exclusions from Warranty
This limited warranty does not cover:
· Damage caused by accidents, abuse, misuse, or neglect
· Unauthorized repairs or servicing by anyone other than Orateeth or an authorized service provider
· Modifications made without Orateeth’s written consent
· Damage caused by non-Orateeth accessories or by failure to use Orateeth-approved accessories
Environmental Considerations
Orateeth is committed to environmental sustainability. Products may contain recyclable electronic components or batteries. Customers are encouraged not to dispose of these products in household waste but to take them to designated electronic waste collection points in their country for proper recycling.
How to Make a Warranty Claim
To initiate a warranty claim, please contact Orateeth Customer Service at support@Orateeth.com. Ensure you provide:
· Proof of purchase (original sales receipt)
· Extended warranty confirmation email
· A detailed description of the defect
*Orateeth reserves the right to interpret, amend, or clarify the terms of this warranty policy in compliance with applicable laws in the European Union and the United Kingdom. This policy does not affect your statutory rights under applicable consumer protection laws.
*Orateeth reserves the right to determine the eligibility of the product for the 1-year extended warranty, based on factors including, but not limited to, the purchase channel, purchase time, purchase model, and other relevant criteria.
Disclaimer: *This warranty policy applies only to Orateeth's main devices (toothbrushes and water flossers), does not cover brush heads, nozzles, or any other accessories.








Product Feature

Why You’ll Love It
Space capsule, beautiful inside and out, enjoy your life.
UV sterilization space capsule, multifunctional sterilization and storage.
Not only vibrates fast, but also cleans more cleanly.

Designed for Your Needs
Long-lasting power for months of effortless use.
Get a thorough clean in just a minute for busy mornings.
Quiet, ultrasonic technology for a peaceful brushing experience.
90s smart sterilization ensures a germ-free brush every time.